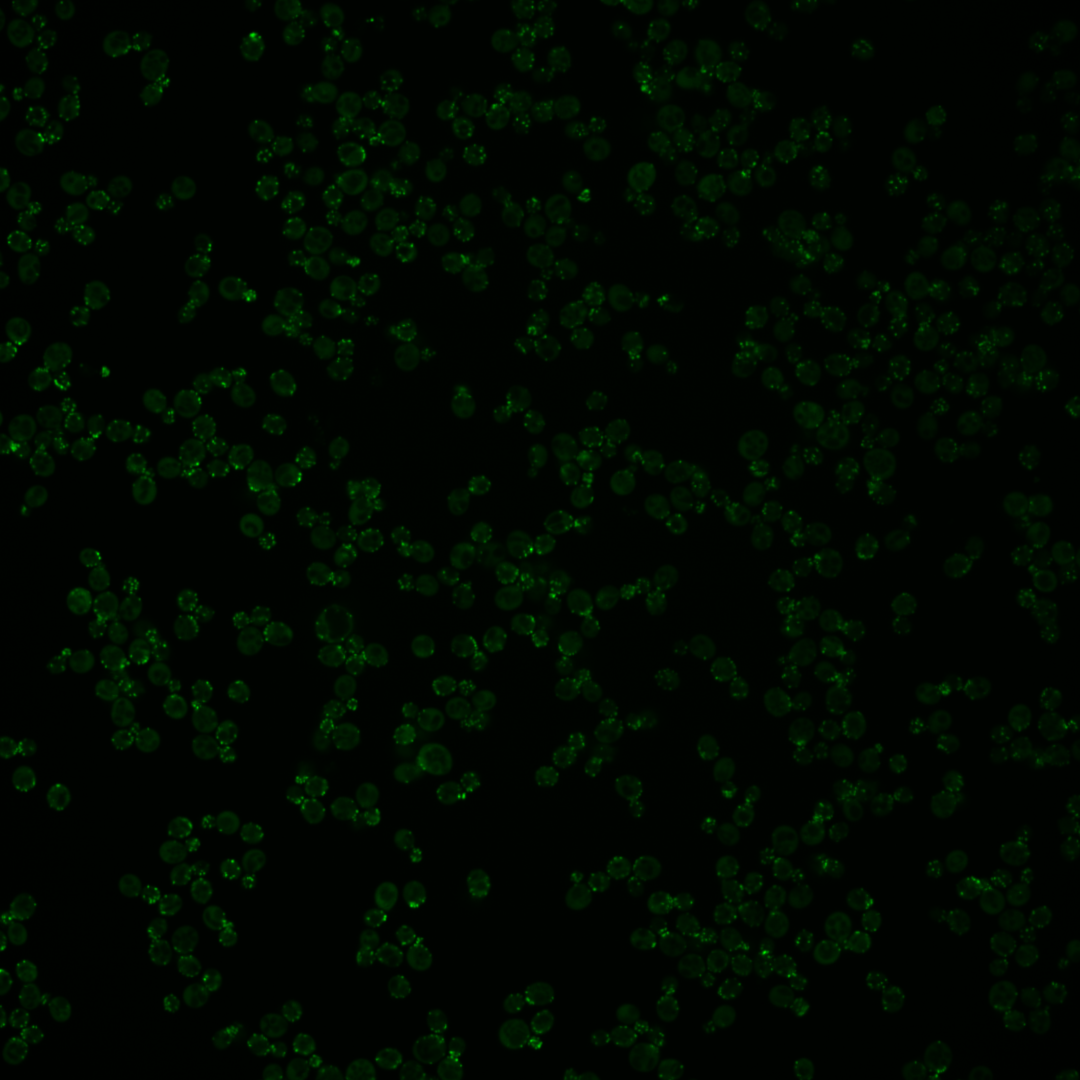

| Standard name | |
|---|---|
| Human Ortholog | |
| Description | Fimbrin, actin-bundling protein; cooperates with Scp1p in organization and maintenance of the actin cytoskeleton; phosphorylated by Cdc28p/Clb2p in metaphase on T103, to regulate conformation, and modulate actin filament binding affinity and actin cable dynamics; relocalizes from the plasma membrane to the cytoplasm upon DNA replication stress; human homologs PLS3 and LCP1 implicated in spinocerebellar ataxia type 2 (SCA2) can each complement yeast null mutant |
Micrographs




















































































Sub-cellular Localization
Yeast GFP Assignment
Protein Abundance
Localization Change
External localization resources
| ensLOC | DeepLoc | |||||||||||||||||||||||
|---|---|---|---|---|---|---|---|---|---|---|---|---|---|---|---|---|---|---|---|---|---|---|---|---|
| Localization | WT1 | WT2 | WT3 | RAP60 | RAP140 | RAP220 | RAP300 | RAP380 | RAP460 | RAP540 | RAP620 | RAP700 | HU80 | HU120 | HU160 | rpd3Δ_1 | rpd3Δ_2 | rpd3Δ_3 | WT1 | WT2 | WT3 | AF100 | AF140 | AF180 |
| Cortical Patches | 41 | 97 | 132 | 115 | 127 | 175 | 186 | 168 | 184 | 187 | 180 | 165 | 108 | 175 | 183 | 52 | 53 | 39 | 90 | 222 | 324 | 280 | 501 | 474 |
| Bud | 9 | 28 | 43 | 42 | 48 | 50 | 60 | 73 | 54 | 64 | 62 | 54 | 27 | 33 | 34 | 6 | 8 | 10 | 6 | 26 | 13 | 15 | 15 | 14 |
| Bud Neck | 0 | 0 | 0 | 0 | 0 | 0 | 0 | 0 | 0 | 0 | 0 | 0 | 0 | 0 | 0 | 0 | 1 | 0 | 0 | 2 | 0 | 2 | 3 | 2 |
| Bud Site | 1 | 0 | 3 | 2 | 0 | 2 | 3 | 3 | 1 | 3 | 2 | 2 | 1 | 0 | 0 | 0 | 0 | 0 | – | – | – | – | – | – |
| Cell Periphery | 4 | 15 | 21 | 14 | 9 | 15 | 21 | 22 | 12 | 19 | 15 | 7 | 15 | 47 | 45 | 10 | 5 | 8 | 0 | 0 | 0 | 0 | 0 | 2 |
| Cytoplasm | 10 | 24 | 17 | 15 | 16 | 13 | 11 | 15 | 9 | 15 | 6 | 8 | 15 | 39 | 25 | 8 | 5 | 9 | 3 | 3 | 4 | 1 | 4 | 1 |
| Endoplasmic Reticulum | 5 | 25 | 12 | 4 | 16 | 20 | 14 | 28 | 11 | 18 | 10 | 15 | 22 | 23 | 23 | 9 | 7 | 9 | 0 | 2 | 1 | 2 | 4 | 9 |
| Endosome | 0 | 0 | 3 | 0 | 0 | 0 | 0 | 0 | 0 | 1 | 0 | 1 | 0 | 0 | 1 | 0 | 0 | 1 | 1 | 6 | 5 | 13 | 18 | 16 |
| Golgi | 35 | 88 | 145 | 126 | 158 | 157 | 234 | 256 | 265 | 198 | 206 | 202 | 132 | 327 | 397 | 108 | 82 | 77 | 5 | 21 | 28 | 39 | 71 | 60 |
| Mitochondria | 13 | 19 | 65 | 19 | 19 | 209 | 196 | 132 | 143 | 193 | 174 | 186 | 6 | 0 | 1 | 24 | 17 | 11 | 0 | 1 | 1 | 4 | 9 | 6 |
| Nucleus | 0 | 0 | 0 | 0 | 0 | 0 | 0 | 0 | 0 | 0 | 0 | 0 | 0 | 1 | 0 | 0 | 0 | 1 | 1 | 0 | 0 | 0 | 0 | 0 |
| Nuclear Periphery | 0 | 0 | 1 | 0 | 0 | 0 | 0 | 0 | 0 | 0 | 0 | 0 | 0 | 0 | 0 | 0 | 0 | 0 | 0 | 0 | 0 | 1 | 0 | 0 |
| Nucleolus | 3 | 2 | 11 | 4 | 11 | 20 | 45 | 46 | 14 | 41 | 17 | 24 | 0 | 4 | 3 | 2 | 2 | 2 | 0 | 0 | 1 | 0 | 0 | 0 |
| Peroxisomes | 0 | 1 | 11 | 1 | 0 | 2 | 4 | 0 | 1 | 6 | 2 | 3 | 1 | 0 | 3 | 1 | 0 | 0 | 0 | 1 | 27 | 25 | 33 | 38 |
| SpindlePole | 0 | 1 | 4 | 3 | 4 | 2 | 4 | 7 | 1 | 3 | 1 | 1 | 1 | 8 | 3 | 0 | 0 | 2 | 0 | 0 | 2 | 0 | 3 | 3 |
| Vac/Vac Membrane | 0 | 1 | 3 | 1 | 3 | 0 | 3 | 0 | 1 | 0 | 0 | 1 | 0 | 4 | 4 | 1 | 1 | 3 | 0 | 3 | 0 | 1 | 3 | 0 |
| Unique Cell Count | 80 | 208 | 299 | 217 | 273 | 440 | 529 | 526 | 438 | 505 | 411 | 432 | 217 | 430 | 500 | 142 | 114 | 118 | 111 | 295 | 415 | 394 | 673 | 637 |
| Labelled Cell Count | 121 | 301 | 471 | 346 | 411 | 665 | 781 | 750 | 696 | 748 | 675 | 669 | 328 | 661 | 722 | 221 | 181 | 172 | 111 | 295 | 415 | 394 | 673 | 637 |
Yeast GFP Assignment
Protein Abundance
| Screen | WT1 | WT2 | WT3 | RAP60 | RAP140 | RAP220 | RAP300 | RAP380 | RAP460 | RAP540 | RAP620 | RAP700 | HU80 | HU120 | HU160 | rpd3Δ_1 | rpd3Δ_2 | rpd3Δ_3 | AF100 | AF140 | AF180 |
|---|---|---|---|---|---|---|---|---|---|---|---|---|---|---|---|---|---|---|---|---|---|
| Mean Cell GFP Intensity (1e-4) | 39.7 | 39.0 | 34.0 | 34.7 | 35.9 | 35.9 | 37.2 | 39.3 | 40.9 | 39.7 | 38.8 | 38.1 | 38.6 | 44.7 | 46.0 | 51.6 | 52.3 | 51.6 | 33.7 | 34.7 | 40.4 |
| Std Deviation (1e-4) | 10.2 | 12.7 | 10.8 | 11.4 | 12.3 | 10.8 | 11.5 | 12.6 | 14.2 | 13.7 | 13.7 | 13.4 | 11.8 | 13.5 | 15.7 | 16.8 | 19.9 | 20.2 | 11.4 | 9.4 | 12.6 |
| Intensity Change (Log2) | – | – | – | 0.03 | 0.08 | 0.08 | 0.13 | 0.21 | 0.27 | 0.22 | 0.19 | 0.16 | 0.18 | 0.39 | 0.44 | 0.6 | 0.62 | 0.6 | -0.01 | 0.03 | 0.25 |
Localization Change
| Localization | RAP60 | RAP140 | RAP220 | RAP300 | RAP380 | RAP460 | RAP540 | RAP620 | RAP700 | HU80 | HU120 | HU160 | rpd3Δ_1 | rpd3Δ_2 | rpd3Δ_3 |
|---|---|---|---|---|---|---|---|---|---|---|---|---|---|---|---|
| Cortical Patches | 2.0 | 0.6 | -1.2 | -2.6 | -3.5 | -0.6 | -2.0 | -0.1 | -1.6 | 1.3 | -0.9 | -2.1 | -1.5 | 0.4 | -2.1 |
| Bud | 1.5 | 1.0 | -1.2 | -1.3 | -0.2 | -0.8 | -0.7 | 0.3 | -0.7 | -0.6 | -2.9 | -3.5 | -3.2 | -2.0 | -1.6 |
| Bud Neck | 0 | 0 | 0 | 0 | 0 | 0 | 0 | 0 | 0 | 0 | 0 | 0 | 0 | 0 | 0 |
| Bud Site | 0 | 0 | 0 | 0 | 0 | 0 | 0 | 0 | 0 | 0 | 0 | 0 | 0 | 0 | 0 |
| Cell Periphery | -0.3 | -2.0 | -2.2 | -1.9 | -1.8 | -2.8 | -2.1 | -2.0 | -3.7 | 0 | 1.8 | 1.0 | 0 | -1.0 | -0.1 |
| Cytoplasm | 0.6 | 0.1 | -1.8 | -2.8 | -2.0 | -2.6 | -1.9 | -3.1 | -2.8 | 0.6 | 1.7 | -0.4 | 0 | -0.5 | 0.7 |
| Endoplasmic Reticulum | -1.4 | 1.0 | 0.3 | -1.1 | 0.8 | -1.2 | -0.3 | -1.2 | -0.4 | 2.8 | 0.8 | 0.4 | 1.1 | 0.9 | 1.5 |
| Endosome | 0 | 0 | 0 | 0 | 0 | 0 | 0 | 0 | 0 | 0 | 0 | 0 | 0 | 0 | 0 |
| Golgi | 2.1 | 2.2 | -3.5 | -1.2 | 0 | 3.2 | -2.6 | 0.4 | -0.5 | 2.8 | 7.7 | 9.1 | 5.5 | 4.3 | 3.1 |
| Mitochondria | -3.9 | -5.0 | 7.1 | 4.6 | 1.1 | 3.2 | 4.8 | 5.7 | 6.0 | -6.2 | -10.1 | -10.7 | -1.2 | -1.6 | -3.0 |
| Nucleus | 0 | 0 | 0 | 0 | 0 | 0 | 0 | 0 | 0 | 0 | 0 | 0 | 0 | 0 | 0 |
| Nuclear Periphery | 0 | 0 | 0 | 0 | 0 | 0 | 0 | 0 | 0 | 0 | 0 | 0 | 0 | 0 | 0 |
| Nucleolus | -1.2 | 0.2 | 0.6 | 2.7 | 2.8 | -0.4 | 2.5 | 0.3 | 1.2 | 0 | -2.6 | -3.2 | 0 | 0 | 0 |
| Peroxisomes | -2.4 | -3.2 | -3.3 | -3.0 | 0 | 0 | -2.4 | -3.1 | -2.9 | -2.4 | 0 | -3.2 | 0 | 0 | 0 |
| SpindlePole | 0 | 0 | 0 | 0 | 0 | 0 | 0 | 0 | 0 | 0 | 0 | 0 | 0 | 0 | 0 |
| Vacuole | 0 | 0 | 0 | 0 | 0 | 0 | 0 | 0 | 0 | 0 | 0 | 0 | 0 | 0 | 0 |
External localization resources
Images






























Protein Concentration and Protein Localization Data
| R1 | R2 | R3 | ||||||||||||||||
|---|---|---|---|---|---|---|---|---|---|---|---|---|---|---|---|---|---|---|
| G1 Pre-START | G1 Post-START | S/G2 | Metaphase | Anaphase | Telophase | G1 Pre-START | G1 Post-START | S/G2 | Metaphase | Anaphase | Telophase | G1 Pre-START | G1 Post-START | S/G2 | Metaphase | Anaphase | Telophase | |
| Concentration | 35.1473 | 35.3646 | 33.943 | 34.5204 | 36.8282 | 36.2046 | 35.578 | 39.6874 | 38.256 | 37.2719 | 33.7113 | 37.2968 | 35.7093 | 38.0149 | 37.0586 | 36.57 | 35.8222 | 37.1969 |
| Actin | 0.925 | 0.879 | 0.9294 | 0.9098 | 0.9306 | 0.985 | 0.8277 | 0.8687 | 0.9348 | 0.9058 | 0.8717 | 0.9554 | 0.9048 | 0.7799 | 0.9303 | 0.9248 | 0.9979 | 0.9695 |
| Bud | 0.0005 | 0.0037 | 0.0182 | 0.006 | 0.0003 | 0.0002 | 0.0013 | 0.01 | 0.0139 | 0.0104 | 0.0005 | 0.0002 | 0.0009 | 0.0067 | 0.0126 | 0.0022 | 0.0001 | 0.0002 |
| Bud Neck | 0.0007 | 0.001 | 0.0042 | 0.0036 | 0.0001 | 0.0015 | 0.0006 | 0.0005 | 0.0007 | 0.0013 | 0.0005 | 0.0022 | 0.0007 | 0.0033 | 0.0013 | 0.0011 | 0.0001 | 0.0009 |
| Bud Periphery | 0.0006 | 0.0014 | 0.0099 | 0.0122 | 0.0003 | 0.0003 | 0.0013 | 0.0041 | 0.012 | 0.016 | 0.0008 | 0.0001 | 0.0008 | 0.0031 | 0.0102 | 0.002 | 0.0001 | 0.0002 |
| Bud Site | 0.001 | 0.0229 | 0.0072 | 0.0008 | 0.0002 | 0.0001 | 0.006 | 0.0247 | 0.0032 | 0.0019 | 0.001 | 0.0001 | 0.0034 | 0.0617 | 0.0052 | 0.0017 | 0.0002 | 0.0004 |
| Cell Periphery | 0.0002 | 0.0003 | 0.0005 | 0.0007 | 0 | 0 | 0.0003 | 0.0008 | 0.0005 | 0.0013 | 0.0001 | 0 | 0.0002 | 0.0016 | 0.0005 | 0.0001 | 0 | 0 |
| Cytoplasm | 0.0018 | 0.0421 | 0.0144 | 0.0007 | 0 | 0 | 0.0035 | 0.0314 | 0.0025 | 0.0036 | 0.0019 | 0.0016 | 0.0024 | 0.078 | 0.0162 | 0.0021 | 0 | 0 |
| Cytoplasmic Foci | 0.0036 | 0.0164 | 0.0034 | 0.0019 | 0.0003 | 0.0002 | 0.0308 | 0.0121 | 0.0044 | 0.0088 | 0.0179 | 0.0017 | 0.0041 | 0.0198 | 0.0078 | 0.0528 | 0.0002 | 0.0003 |
| Eisosomes | 0.0042 | 0.0005 | 0.0008 | 0.001 | 0.0147 | 0.0015 | 0.0035 | 0.0004 | 0.0006 | 0.0022 | 0.0005 | 0.0012 | 0.002 | 0.0006 | 0.0017 | 0.0003 | 0.0003 | 0.0011 |
| Endoplasmic Reticulum | 0.0008 | 0.0001 | 0.0001 | 0.0001 | 0 | 0 | 0.0031 | 0.0001 | 0.0009 | 0.0003 | 0.0004 | 0 | 0.0051 | 0.0005 | 0.0002 | 0 | 0 | 0 |
| Endosome | 0.0032 | 0.0024 | 0.0017 | 0.0011 | 0.0004 | 0.0002 | 0.0172 | 0.0013 | 0.0067 | 0.0184 | 0.0111 | 0.0004 | 0.0205 | 0.012 | 0.0013 | 0.0008 | 0 | 0.0006 |
| Golgi | 0.0367 | 0.0155 | 0.0061 | 0.0579 | 0.0522 | 0.0105 | 0.0333 | 0.0274 | 0.0062 | 0.0171 | 0.005 | 0.0217 | 0.0388 | 0.0174 | 0.0029 | 0.0038 | 0.0005 | 0.026 |
| Lipid Particles | 0.0013 | 0.0052 | 0.001 | 0.0004 | 0.0002 | 0 | 0.0097 | 0.0012 | 0.0011 | 0.0018 | 0.0064 | 0.0058 | 0.0032 | 0.0016 | 0.0008 | 0.0017 | 0 | 0 |
| Mitochondria | 0.0078 | 0.0014 | 0.0015 | 0.0011 | 0.0002 | 0.0001 | 0.0248 | 0.0005 | 0.0063 | 0.0059 | 0.0524 | 0.0005 | 0.0037 | 0.0029 | 0.0035 | 0.0009 | 0.0001 | 0.0004 |
| None | 0.0018 | 0.0001 | 0 | 0 | 0 | 0 | 0.0036 | 0 | 0.0003 | 0.0001 | 0.0004 | 0.0001 | 0.0003 | 0.0001 | 0.0004 | 0.0001 | 0 | 0 |
| Nuclear Periphery | 0.0021 | 0.0006 | 0.0001 | 0 | 0 | 0 | 0.0054 | 0.0001 | 0.0019 | 0.0002 | 0.0006 | 0.0001 | 0.0031 | 0.0006 | 0.0005 | 0 | 0 | 0 |
| Nucleolus | 0.0008 | 0.0001 | 0 | 0.0001 | 0 | 0 | 0.0028 | 0 | 0.0001 | 0 | 0.0003 | 0.0051 | 0.0001 | 0.0001 | 0.0002 | 0 | 0 | 0 |
| Nucleus | 0.0016 | 0.0001 | 0.0001 | 0.0001 | 0 | 0 | 0.0033 | 0.0001 | 0.0005 | 0.0001 | 0.0003 | 0.0005 | 0.0004 | 0.0003 | 0.0004 | 0 | 0 | 0 |
| Peroxisomes | 0.0007 | 0.0061 | 0.0008 | 0.002 | 0.0004 | 0.0002 | 0.0141 | 0.015 | 0.002 | 0.0033 | 0.0256 | 0.0021 | 0.002 | 0.0043 | 0.0023 | 0.005 | 0.0004 | 0.0003 |
| Punctate Nuclear | 0.0033 | 0.0001 | 0 | 0 | 0 | 0 | 0.0048 | 0.0001 | 0.0007 | 0.0001 | 0.0006 | 0.001 | 0.0003 | 0.0002 | 0.0001 | 0.0003 | 0 | 0 |
| Vacuole | 0.0008 | 0.0003 | 0.0004 | 0.0003 | 0 | 0 | 0.0014 | 0.001 | 0.0005 | 0.0009 | 0.0012 | 0 | 0.0022 | 0.0029 | 0.0012 | 0.0001 | 0 | 0 |
| Vacuole Periphery | 0.0012 | 0.0006 | 0.0002 | 0.0001 | 0 | 0 | 0.0017 | 0.0002 | 0.0003 | 0.0005 | 0.001 | 0.0001 | 0.0009 | 0.0023 | 0.0004 | 0 | 0 | 0 |
Sequencing Data
| R1 | R2 | |||||||||
|---|---|---|---|---|---|---|---|---|---|---|
| G1 Post-START | S/G2 | Metaphase | Anaphase | Telophase | G1 Post-START | S/G2 | Metaphase | Anaphase | Telophase | |
| Gene Expression | 152.4403 | 132.9486 | 120.2815 | 143.198 | 134.9774 | 141.7796 | 128.737 | 121.9584 | 144.1714 | 140.3764 |
| Translational Efficiency | 2.0564 | 1.9028 | 1.9768 | 2.1474 | 1.9756 | 2.1952 | 1.7833 | 1.7802 | 1.7629 | 1.7139 |
Hit Data
| Dataset | Hit |
|---|---|
| Protein Concentration | ✘ |
| Protein Localization | ✘ |
| Gene Expression | ✘ |
| Translational Efficiency | ✘ |
Endocytosis
| Temp | Actin Patch (Sac6-tdTomato) | Cortical Patch (Sla1-GFP) | Late Endosome (Snf7-GFP) | Vacuole (Vph1-GFP) |
|---|---|---|---|---|
| 37℃ | ||||
| RT |
Cell Cycle Omics
CYCLoPs (Sac6-GFP)
| Gene / Allele | Actin Patch (Sac6-tdTomato) | Cortical Patch (Sla1-GFP) | Late Endosome (Snf7-GFP) | Vacuole (Sac6-tdTomato) |
|---|
| Gene | Images |
|---|
| Gene | Images |
|---|
Images are not yet available
Images are not yet available